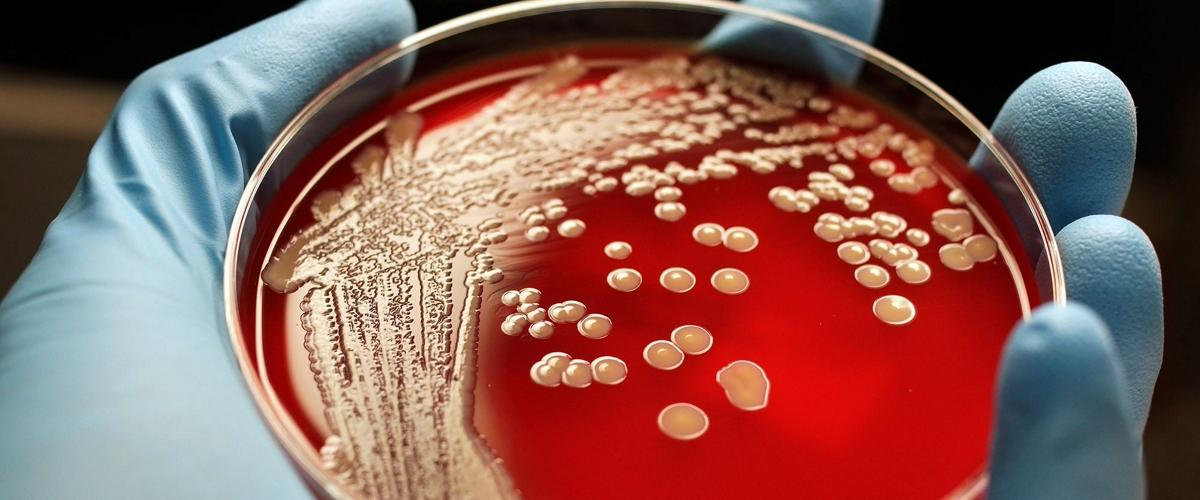
TODO:

В сухих и жарких регионах США, например, на юго-западе страны, нередки случаи так называемой долинной, или калифорнийской, лихорадки. Это заболевание вызывают два вида грибков из рода Coccidioides. Обычно они живут в почве, но их споры могут попадать в легкие и вызывать целый ряд неприятных симптомов — кашель, озноб и ночную потливость.
В тяжелых случаях болезнь переходит на кожу и другие органы и требует серьезного лечения. При этом 1% спасти зараженных не удается.
Чаще всего от долинной лихорадки страдают фермеры, дорожные рабочие и пожарные, работающие на открытом воздухе. Однако наибольший урон грибок способен принести детям, беременным женщинам и ВИЧ-инфицированным. Кроме того, уязвимы афроамериканцы и потомки филиппинцев.
Согласно новому исследованию, о котором рассказывает Science Daily, в текущем столетии территория распространения этой болезни увеличится более чем вдвое. Всему виной глобальное потепление.
Изучив температурные предпочтения грибков и сравнив их с климатическими моделями, специалисты из Калифорнийского университета в Ирвайне пришли к выводу, что к 2100 году болезнь распространится по всему западу США. Число затронутых штатов вырастет с 12 до 17, а ежегодное количество заболевших увеличится в полтора раза.
Первые признаки грядущих изменений заметны уже сегодня — число случаев долинной лихорадки в последние годы неуклонно росло.
Долинная лихорадка — не единственная грибковая болезнь, распространению которой способствует глобальное потепление. Например, мирный грибок Candida auris, приспособившись к изменившимся условиям среды, начал атаковать людей и «осваивает» больницы. Многие штаммы приобрели устойчивость к противогрибковым препаратам и убивают от 30% до 60% зараженных.